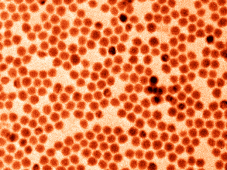

Home > Press > Antimony nanocrystals for batteries
|
| TEM image (false coloured) of monodisperse antimony nanocrystals. Photo: Maksym Kovalenko Group / ETH Zurich |
Abstract:
Researchers from ETH Zurich and Empa have succeeded for the first time to produce uniform antimony nanocrystals. Tested as components of laboratory batteries, these are able to store a large number of both lithium and sodium ions. These nanomaterials operate with high rate and may eventually be used as alternative anode materials in future high-energy-density batteries.
Antimony nanocrystals for batteries
Zurich, Switzerland | Posted on March 18th, 2014The hunt is on - for new materials to be used in the next generation of batteries that may one day replace current lithium ion batteries. Today, the latter are commonplace and provide a reliable power source for smartphones, laptops and many other portable electrical devices.
On the one hand, however, electric mobility and stationary electricity storage demand a greater number of more powerful batteries; and the high demand for lithium may eventually lead to a shortage of the raw material. This is why conceptually identical technology based on sodium-ions will receive increasing attention in coming years. Contrary to lithium batteries, researched for more than 20 years, much less is known about materials that can efficiently store sodium ions.
Antimony electrodes?
A team of researchers from ETH Zurich and Empa headed by Maksym Kovalenko may have come a step closer to identifying alternative battery materials: they have become the first to synthesise uniform antimony nanocrystals, the special properties of which make them prime candidates for an anode material for both lithium-ion and sodium-ion batteries. The results of the scientists' study have just been published in Nano Letters.
For a long time, antimony has been regarded as a promising anode material for high-performance lithium-ion batteries as this metalloid exhibits a high charging capacity, by a factor of two higher than that of commonly used graphite. Initial studies revealed that antimony could be suitable for rechargeable lithium and sodium ion batteries because it is able to store both kinds of ions. Sodium is regarded as a possible low-cost alternative to lithium as it is much more naturally abundant and its reserves are more evenly distributed on Earth.
For antimony to achieve its high storage capability, however, it needs to be produced in a special form. The researchers managed to chemically synthesize uniform - so-called "monodisperse" - antimony nanocrystals that were between ten and twenty nanometres in size.
The full lithiation or sodiation of antimony leads to large volumetric changes. By using nanocrystals, these modulations of the volume can be reversible and fast, and do not lead to the immediate fracture of the material. An additional important advantage of nanocrystals (or nanoparticles) is that they can be intermixed with a conductive carbon filler in order to prevent the aggregation of the nanoparticles.
Ideal candidate for anode material
Electrochemical tests showed Kovalenko and his team that electrodes made of these antimony nanocrystals perform equally well in sodium and in lithium ion batteries. This makes antimony particularly promising for sodium batteries because the best lithium-storing anode materials (Graphite and Silicon) do not operate with sodium.
Highly monodisperse nanocrystals, with the size deviation of ten percent or less, allow identifying the optimal size-performance relationship. Nanocrystals of ten nanometers or smaller suffer from oxidation because of the excessive surface area. On the other hand, antimony crystals with a diameter of more than 100 nanometres aren't sufficiently stable due to aforementioned massive volume expansion and contraction during the operation of a battery. The researchers achieved the best results with 20 nanometer large particles.
Performance not so size dependent
Another important outcome of this study, enabled by these ultra-uniform particles, is that the researchers identified a size-range of around 20 to 100 nanometres within which this material shows excellent, size-independent performance, both in terms of energy density and rate-capability.
These features even allow using polydisperse antimony particles to obtain the same performance as with very monodisperse particles, as long as their sizes remain within this size-range of 20 to 100 nanometres.
"This greatly simplifies the task of finding an economically viable synthesis method", Kovalenko says. "Development of such cost-effective synthesis is the next step for us, together with our industrial partner." Experiments of his group on monodisperse nanoparticles of other materials show much steeper size-performance relationships such as quick performance decay with increasing the particle size, placing antimony into a unique position among the materials which alloy with lithium and sodium.
More expensive alternative
Does this mean that an alternative to today's lithium-ion batteries is within our grasp? Kovalenko shakes his head. Although the method is relatively straightforward, the production of a sufficient number of high-quality uniform antimony nanocrystals is still too expensive.
"All in all, batteries with sodium-ions and antimony nanocrystals as anodes will only constitute a highly promising alternative to today's lithium-ion batteries if the costs of producing the batteries will be comparable," says Kovalenko.
It will be another decade or so before a sodium-ion battery with antimony electrodes could hit the market, the ETH-Zurich professor estimates. The research on the topic is still only in its infancy. "However, other research groups will soon join the efforts," the chemist is convinced.
Lithium-ion batteries
A current lithium-ion battery comprises two electrodes - a cathode and an anode. The anode is often made of graphite, the cathode of metal oxides such as cobalt oxide. The lithium ions lodge themselves in these materials during the charging or discharging processes. The two electrodes are separated by a e wall permeable only for lithium ions traveling between the two electrodes, but not for electrons. During the discharge of a battery, the lithium ions shift from the anode to the cathode. As the electrons do not fit through, they take a detour via an electronic device, which is powered by the resulting electron flux. Electrons and ions meet again in the cathode. When the battery is charging, the ions and electrons are enforced to flow in the opposite direction. For the battery to work effectively and for a long time, the ions need to be able to move in and out of the electrode materials easily. The shape and size of the electrode materials should not change much through the recurrent absorption and release of the ions.
####
For more information, please click here
Contacts:
Maksym Kovalenko
41-446-334-156
Copyright © ETH Zurich
If you have a comment, please Contact us.Issuers of news releases, not 7th Wave, Inc. or Nanotechnology Now, are solely responsible for the accuracy of the content.
| Related Links |
| Related News Press |
News and information
![]() Simulating magnetization in a Heisenberg quantum spin chain April 5th, 2024
Simulating magnetization in a Heisenberg quantum spin chain April 5th, 2024
![]() NRL charters Navy�s quantum inertial navigation path to reduce drift April 5th, 2024
NRL charters Navy�s quantum inertial navigation path to reduce drift April 5th, 2024
![]() Discovery points path to flash-like memory for storing qubits: Rice find could hasten development of nonvolatile quantum memory April 5th, 2024
Discovery points path to flash-like memory for storing qubits: Rice find could hasten development of nonvolatile quantum memory April 5th, 2024
Discoveries
![]() Chemical reactions can scramble quantum information as well as black holes April 5th, 2024
Chemical reactions can scramble quantum information as well as black holes April 5th, 2024
![]() New micromaterial releases nanoparticles that selectively destroy cancer cells April 5th, 2024
New micromaterial releases nanoparticles that selectively destroy cancer cells April 5th, 2024
![]() Utilizing palladium for addressing contact issues of buried oxide thin film transistors April 5th, 2024
Utilizing palladium for addressing contact issues of buried oxide thin film transistors April 5th, 2024
Announcements
![]() NRL charters Navy�s quantum inertial navigation path to reduce drift April 5th, 2024
NRL charters Navy�s quantum inertial navigation path to reduce drift April 5th, 2024
![]() Discovery points path to flash-like memory for storing qubits: Rice find could hasten development of nonvolatile quantum memory April 5th, 2024
Discovery points path to flash-like memory for storing qubits: Rice find could hasten development of nonvolatile quantum memory April 5th, 2024
Interviews/Book Reviews/Essays/Reports/Podcasts/Journals/White papers/Posters
![]() Simulating magnetization in a Heisenberg quantum spin chain April 5th, 2024
Simulating magnetization in a Heisenberg quantum spin chain April 5th, 2024
![]() Discovery points path to flash-like memory for storing qubits: Rice find could hasten development of nonvolatile quantum memory April 5th, 2024
Discovery points path to flash-like memory for storing qubits: Rice find could hasten development of nonvolatile quantum memory April 5th, 2024
Battery Technology/Capacitors/Generators/Piezoelectrics/Thermoelectrics/Energy storage
![]() What heat can tell us about battery chemistry: using the Peltier effect to study lithium-ion cells March 8th, 2024
What heat can tell us about battery chemistry: using the Peltier effect to study lithium-ion cells March 8th, 2024
![]() A battery�s hopping ions remember where they�ve been: Seen in atomic detail, the seemingly smooth flow of ions through a battery�s electrolyte is surprisingly complicated February 16th, 2024
A battery�s hopping ions remember where they�ve been: Seen in atomic detail, the seemingly smooth flow of ions through a battery�s electrolyte is surprisingly complicated February 16th, 2024
|
|
||
|
|
||
| The latest news from around the world, FREE | ||
|
|
||
|
|
||
| Premium Products | ||
|
|
||
|
Only the news you want to read!
Learn More |
||
|
|
||
|
Full-service, expert consulting
Learn More |
||
|
|
||








